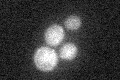
YHR068W
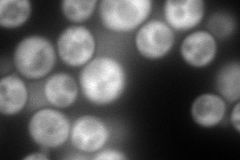
YHR068W
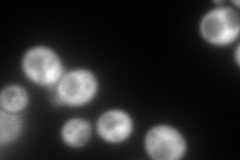
YHR068W
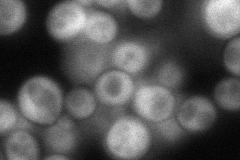
YHR068W
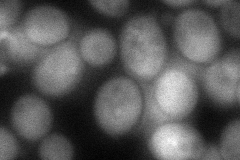
YHR068W
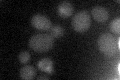
YHR068W

View description
Deoxyhypusine synthase, catalyzes formation of deoxyhypusine, the first step in hypusine biosynthesis; triggers posttranslational hypusination of translation elongation factor eIF-5A and regulates its intracellular levels; tetrameric
Localization:
Intensity:
Fold change:
Significance:
-
C’ GFP library in SD
below threshold18.42 -
N' NOP1pr-GFP in SD
cytosol312.81 -
N' TEF2pr-mCherry in SD
cytosol337.657 -
N' NATIVEpr-GFP in SD
cytosol103.126 -
N' TEF2pr-VC and Cyto-VN in SD
cytosol80.4269 -
C’ GFP library in SD+DTT

cytosolN/AN/ANo -
C’ GFP library in SD+H2O2

cytosol15.570.84No -
C’ GFP library in Starvation Media
cytosol25.011.35No -
C’ GFP library on the background of Pup2-DaMP

below threshold -
C’ GFP library on the background of CCT mutant

below threshold17.75660.963451No
